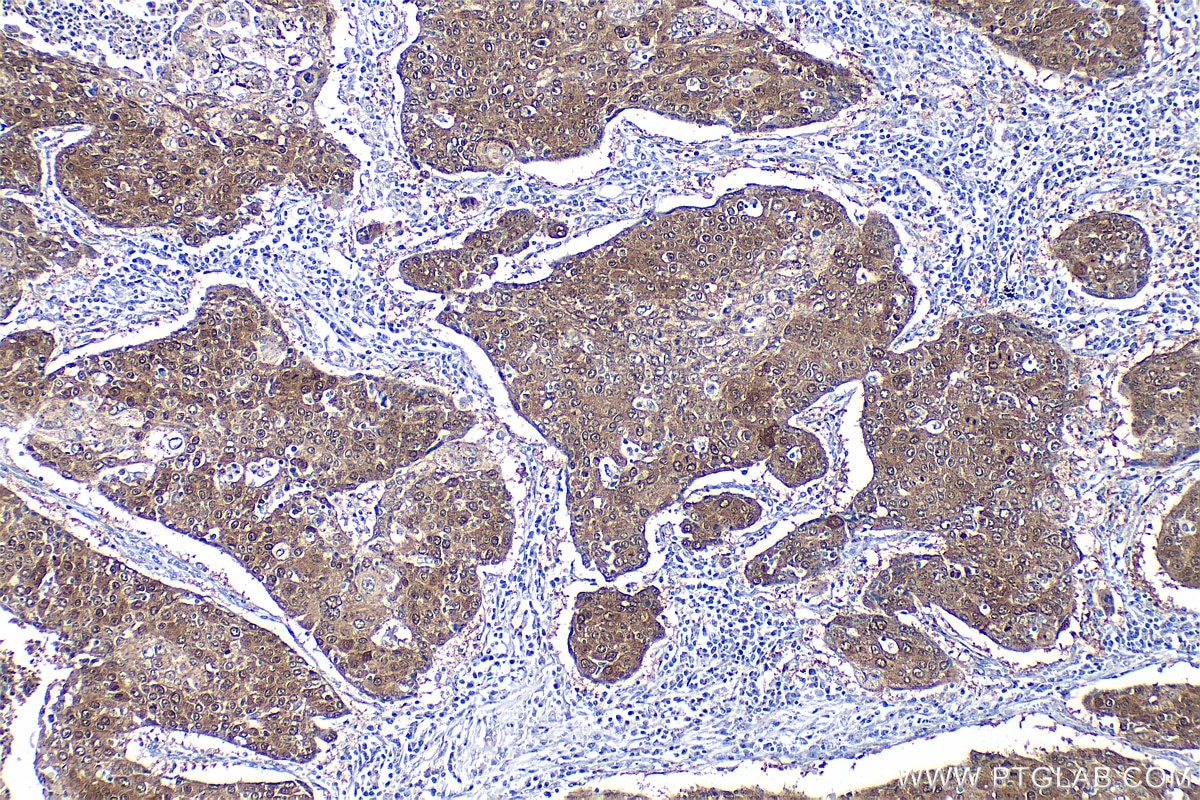
Immunohistochemistry (IHC) staining of human lung cancer tissue using HSPA4L Polyclonal antibody (32468-1-AP)
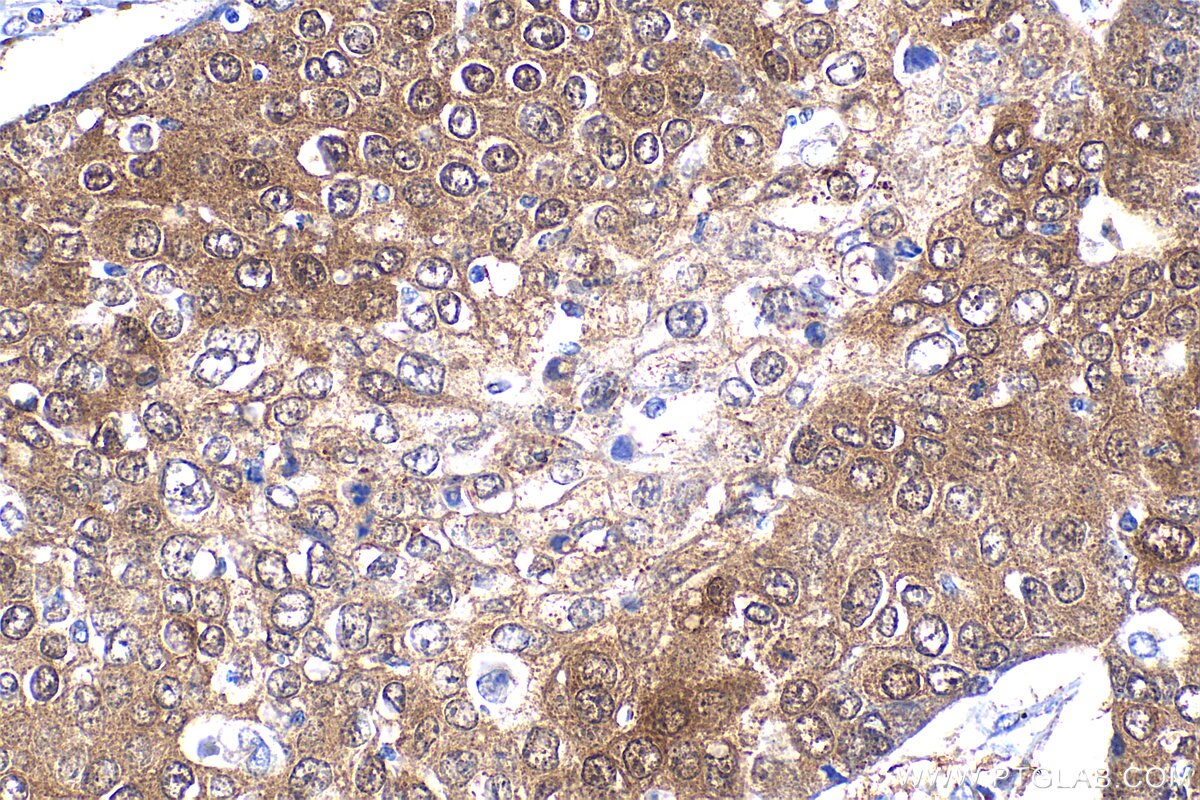
Immunohistochemistry (IHC) staining of human lung cancer tissue using HSPA4L Polyclonal antibody (32468-1-AP)
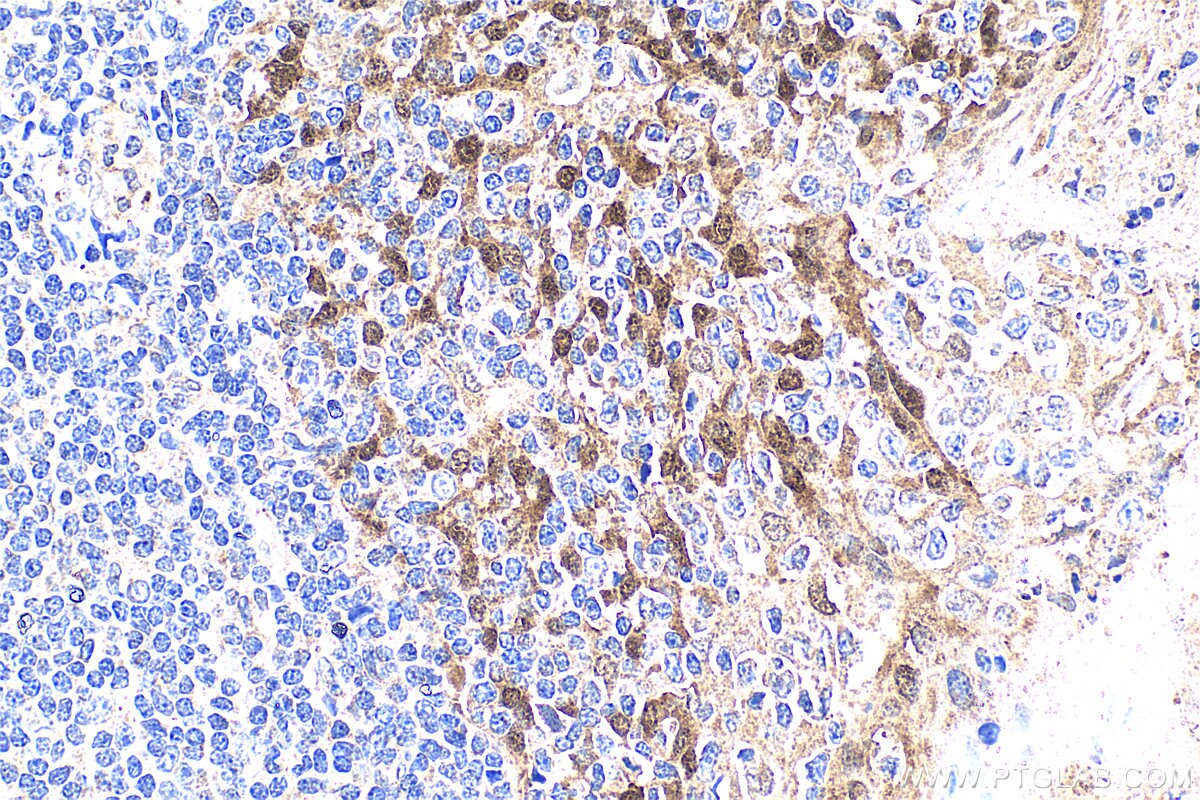
Immunohistochemistry (IHC) staining of human tonsillitis tissue using HSPA4L Polyclonal antibody (32468-1-AP)

Tested Applications
| Positive WB detected in | HL-60 cells, K-562 cells, RT-4 cells, U-251 cells |
| Positive IHC detected in | human tonsillitis tissue, human lung cancer tissue Note: suggested antigen retrieval with TE buffer pH 9.0; (*) Alternatively, antigen retrieval may be performed with citrate buffer pH 6.0 |
Recommended dilution
| Application | Dilution |
|---|---|
| Western Blot (WB) | WB : 1:1000-1:8000 |
| Immunohistochemistry (IHC) | IHC : 1:50-1:500 |
| It is recommended that this reagent should be titrated in each testing system to obtain optimal results. | |
| Sample-dependent, Check data in validation data gallery. | |
Product Information
32468-1-AP targets HSPA4L in WB, IHC, ELISA applications and shows reactivity with human samples.
| Tested Reactivity | human |
| Host / Isotype | Rabbit / IgG |
| Class | Polyclonal |
| Type | Antibody |
| Immunogen |
CatNo: Ag38354 Product name: Recombinant human HSPA4L protein Source: e coli.-derived, PGEX-4T Tag: GST Domain: 690-839 aa of NM_001317381.1 Sequence: MKYMEHEERPKALNDLGKKIQLVMKVIEAYRNKDERYDHLDPTEMEKVEKCISDAMSWLNSKMNAQNKLSLTQDPVVKVSEIVAKSKELDNFCNPIIYKPKPKAEVPEDKPKANSEHNGPMDGQSGTETKSDSTKDSSQHTKSSGEMEVD* Predict reactive species |
| Full Name | heat shock 70kDa protein 4-like |
| Calculated Molecular Weight | 95kDa,839aa |
| Observed Molecular Weight | 95~100 kDa |
| GenBank Accession Number | NM_001317381.1 |
| Gene Symbol | HSPA4L |
| Gene ID (NCBI) | 22824 |
| Conjugate | Unconjugated |
| Form | Liquid |
| Purification Method | Antigen affinity Purification |
| UNIPROT ID | O95757 |
| Storage Buffer | PBS with 0.02% sodium azide and 50% glycerol, pH 7.3. |
| Storage Conditions | Store at -20°C. Stable for one year after shipment. Aliquoting is unnecessary for -20oC storage. 20ul sizes contain 0.1% BSA. |
Background Information
HSPA4L (Heat shock 70-kDa protein 4-like), also known as APG1 or OSP94, is a member of the heat shock protein 110 family, whose mRNA is strongly expressed in normal human testis and overexpressed in leukemia cells. HSPA4L was also restrictedly expressed in normal tissues and the its product was capable of eliciting a humoral immune response likely induced by its high-level expression in leukemia cells. Up-regulation of the Hspa4l gene in kidney and renal cell lines by osmotic stress suggested that Hspa4l may function to enable the kidney to compensate for osmotic stress present within the kidney (PMID: 16923965, 17588478).
Protocols
| Product Specific Protocols | |
|---|---|
| IHC protocol for HSPA4L antibody 32468-1-AP | Download protocol |
| WB protocol for HSPA4L antibody 32468-1-AP | Download protocol |
| Standard Protocols | |
|---|---|
| Click here to view our Standard Protocols |